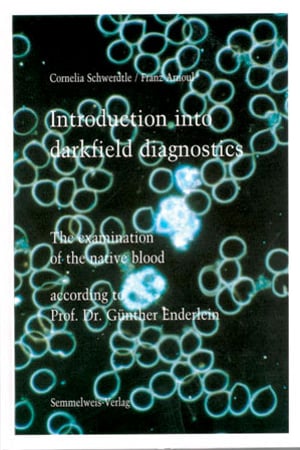

Introduction into Darkfield Diagnostics
Cornelia Schwerdle / Franz Arnoul
This book is based on the findings of Prof. Dr. Guenther Enderlein. The methods developed by Dr. Enderlein for the examination of the native blood in the darkfield microscope have been systematically reworked and supplemented by his own experiences of many years.
ISBN: 3925524479
SKU: BK1411
£39.00